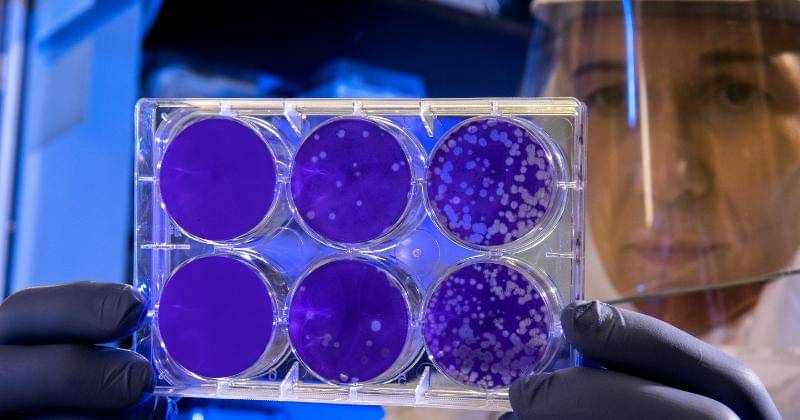
Pexels/CDC
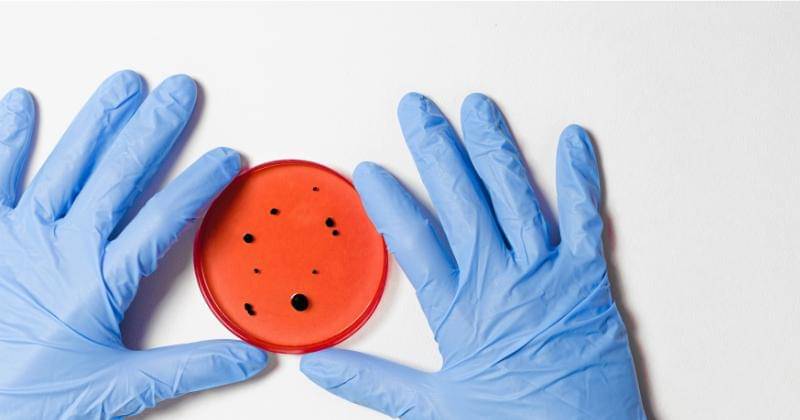
Pexels/Anna Shvets

- Keputihan berwarna putih keabu-abuan dengan konsistensinya encer,
- sakit ketika sedang buar air kecil,
- gatal di sekitar vagina.
Tetap Harus Waspada, Ini Masalah Vagina yang Rentan Terjadi saat Hamil

Jika selama kehamilan terjadi infeksi-infeksi yang mungkin tidak diketahui, Mama jangan khawatir. Sebab infeksi tersebut hal yang umum dalam masa kehamilan.
Salah satunya adalah infeksi vagina. Infeksi ini disebabkan oleh perubahan hormonal yang drastis selama kehamilan yang dapat memberatkan sistem reproduksi.
Jangan khawatir Ma, infeksi vagina ini dapat diatasi dengan mudah jika memang diketahui lebih awal. Maka dari itu, tetap harus waspada ya, Ma.
Jika Mama ingin tahu apa saja masalah vagina yang rentan terjadi saat hamil dan apa saja gejalanya, berikut Popmama.com telah merangkum informasinya yang dikutip dari IDN Times.
1. Vaginosis bakteri
Vaginosis bakterialis adalah infeksi vagina yang terjadi akibat terganggunya keseimbangan flora normal di dalam vagina. Vaginosis bakteri terjadi ketika ada pertumbuhan berlebih bakteri yang biasanya hidup di vagina.
Jika infeksi vagina yang satu ini tidak segera diobati, berakibat pada kelahiran prematur, atau berat badan lahir rendah. Vaginosis bakteri biasanya diobati dengan antibiotik, tetapi kadang-kadang hilang dengan sendirinya.
Untuk lebih mengetahui, berikut adalah beberapa gejala dari vaginosis bakteri:
2. Infeksi jamur

Masalah infeksi vagina selanjutnya adalah infeksi jamur. Infeksi ini disebabkan oleh pertumbuhan jamur Candida yang berlebih.
Menurut Office on Women's Health, pada perempuan hamil, kemungkinan terkena infeksi jamur meningkat.
Kondisi pada infeksi jamur memang tidak menyebabkan komplikasi, namun ada baiknya tetap harus diobati agar tidak mengganggu kenyamanan dan kualitas hidup mama saat hamil.
Adapun gejala dari infeksi jamur diantaranya adalah:
- Keputihan kental berwarna putih,
- pembengkakan pada vagina dan vulva disertai rasa terbakar dan kemerahan,
- sakit ketika buang air kecil,
- sakit saat sedang berhubungan seksual.
3. Trikomoniasis

Trikomoniasis adalah semacam penyakit menular seksual yang disebabkan oleh organisme yang disebut trikomonas vaginalis. Menurut Centers For Disease Control And Prevention (CDC), sekitar 70 persen orang dengan trikomoniasis tidak mengalami gejala apa pun, tetapi masih dapat menularkan infeksi.
Infeksi vagina yang satu ini dapat menyebabkan persalinan dini dan mengakibatkan bayi terlahir dengan berat badan lahir rendah atau prematur. Trikomoniasis biasanya diobati dengan antibiotik oral yang aman dikonsumsi oleh ibu hamil.
Agar lebih waspada, ketahui gejala trikomoniasis:
- Timbulnya rasa gatal, terbakar, kemerahan, atau nyeri pada vagina,
- ketika buang air kecil tidak nyaman,
- keputihan yang jernih, putih, kekuningan, atau kehijauan dengan bau amis yang tidak biasa.
4. Streptokokus grup B
Streptokokus grup B adalah bakteri yang normal ditemukan pada vagina dan rektum, yang banyak ditemukan pada orang dewasa dan tidak menimbulkan bahaya apa pun.
Namun, infeksi ini dapat menyebabkan masalah pada orang dengan penyakit kronis, seperti diabetes atau penyakit jantung, keguguran dan infeksi serius pada bayi.
Ibu hamil yang terinfeksi bakteri streptokokus grup B biasanya menunjukkan gejala berikut:
- Infeksi kulit dan jaringan halus,
- infeksi paru (pneumonia),
- infeksi saluran kemih,
- meningitis atau radang selaput otak,
- sepsis (komplikasi akibat infeksi).
5. Infeksi saluran kemih

Infeksi saluran kemih adalah kondisi di mana terjadinya infeksi pada organ yang termasuk di dalam sistem kemih, yaitu ureter, ginjal, kandung kemih, dan juga uretra. Dapat terjadi ketika bakteri dari luar masuk ke saluran kemih dan menyebabkan infeksi.
Umumnya, infeksi ini terjadi pada ibu hamil karena janin yang terus tumbuh dapat memberi tekanan pada kandung kemih dan menjebak bakteri.
Selain itu, infeksi ini membuat urine terperangkap di uretra lebih lama. Jika ini tidak diobati, infeksi dapat menyebar ke ginjal dan menyebabkan kerusakan permanen. Untuk mengatasi infeksi ini, ibu hamil biasanya diresepkan dengan antibiotik.
Mama dapat mengetahui gejala-gejalanya sebagai berikut:
- Rasa terbakar atau sakit saat buang air kecil,
- urine berwarna keruh atau bercampur darah,
- nyeri panggul atau punggung bawah,
- sering buang air kecil,
- sering merasa ingin buang air kecil,
- demam,
- mual dan muntah.
Demikianlah berbagai masalah vagina yang rentan terjadi saat hamil. Jangan lupa selalu periksa ke dokter setiap merasakan gejala dari salah satunya, lebih baik untuk melakukan pengobatan lebih awal.














































